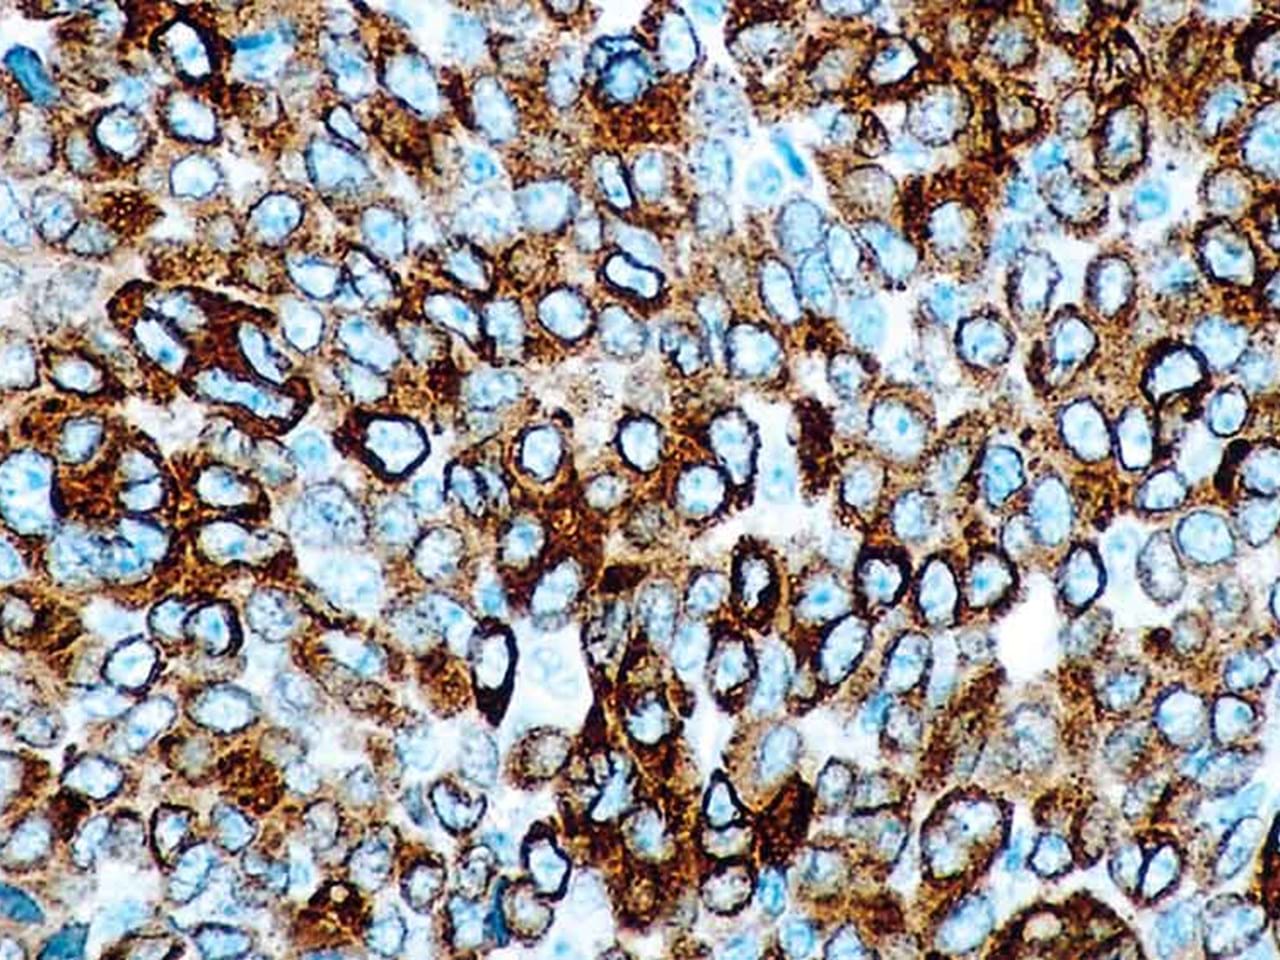

Årsmøte for Norsk forening for klinisk cytologi (NFKC) 2025

Årsmøte for Norsk forening for klinisk cytologi (NFKC) 2025
Vi deltar på Årsmøtet for Norsk Forening for Klinisk Cytologi (NFKC) 2025. Besøk oss på vår stand for en prat om våre produkter og løsninger.
Medisinsk Teknologisk Forening Landsmøte 2025

Medisinsk Teknologisk Forening Landsmøte 2025
Møt oss på Medisinsk Teknologisk Forening Landsmøte 2025, 21.–23. mai i Bergen. Du finner oss på stand nr. 25, hvor vi vil presentere spennende produkter og løsninger.
Jubileumsmesse - Helseservice 40 år

Jubileumsmesse - Helseservice 40 år
Fagdager arrangert av Norengros Helseservice, i anledning deres 40 års jubileum, 3-4. juni på Hurtigrutens Hus i Stokmarknes. Flere fagforedrag fra ulike leverandører er planlagt. Triolab gleder seg til å feire med Helseservice og ta imot leger og medarbeidere på vår stand.
LabDays 2025

LabDays 2025
Vi skal ha stand på LabDays 2025! Besøk oss for en prat om våre løsninger og nyheter. Mer informasjon kommer – vi gleder oss til å se deg der!
Tidligere arrangementer
Røros-kurs - Noklus

Røros-kurs - Noklus
Emnekurs for leger og tellende timer for medarbeidere på legekontor 4-5 april på Røros Hotell, med firmautstilling. Arrangert av Noklus. Triolab vil presentere ulike instrumenter som er nyttig både ved sår- og infeksjonsdiagnostikk. Begge temaer er aktuelle under kurset.
Mikrobiologisk hurtigdiagnostikk

Mikrobiologisk hurtigdiagnostikk
Vi ser frem til å delta som utstiller på Mikrobiologisk hurtigdiagnostikk, hvor vi vil presentere våre løsninger innen rask og presis diagnostisering.
Årsmøte Den norske patologforening

Årsmøte Den norske patologforening
Møt vår produktsjef Pål Bodin på stand under årsmøtet i Legenes Hus, Oslo.
Servicekurs ABL90 for brukere og medisinteknikere | 13.02.2025

Servicekurs ABL90 for brukere og medisinteknikere | 13.02.2025
Vi arrangerer servicekurs på ABL90. Kursene blir holdt av våre egne serviceingeniører som har lang erfaring med blodgassinstrumenter.
Servicekurs ABL800 for brukere og medisinteknikere | 11. - 12.02.2025

Servicekurs ABL800 for brukere og medisinteknikere | 11. - 12.02.2025
Vi arrangerer servicekurs på ABL90. Kursene blir holdt av våre egne serviceingeniører som har lang erfaring med blodgassinstrumenter.
Servicekurs ABL90 for brukere og medisinteknikere | 10.02.2025

Servicekurs ABL90 for brukere og medisinteknikere | 10.02.2025
Vi arrangerer servicekurs på ABL90. Kursene blir holdt av våre egne serviceingeniører som har lang erfaring med blodgassinstrumenter.
Infobruk Konferansen 2025

Infobruk Konferansen 2025
Besøk vår stand der vi vil ha fokus på oppkobling av lab-instrumenter til journalsystemer. Vi vil presentere vårt tilkoblede laboratorium med full sporbarhet.
Histoteknikerforeningens seminar 2025
Histoteknikerforeningens seminar 2025
Møt oss på stand under Histoteknikerforeningens seminar på Hotel Clarion The HUB, Oslo
Norsk konferanse i Massespektrometri

Norsk konferanse i Massespektrometri
Møt vår produktsjef Kristian Wittek på stand under konferansen.
NBS Contact Meeting 2025

NBS Contact Meeting 2025
Møt vår produktsjef Morten Thorsholt på NBS kontaktmøte.
Helsekonferansen 2025 - Norengros K. J. Brusdal

Helsekonferansen 2025 - Norengros K. J. Brusdal
Vi stiller opp med stand på vår samarbeidspartner K. J. Brusdal sin store Helsekonferanse 2025.
Nasjonalt fagmøte i genetikk

Nasjonalt fagmøte i genetikk
Møt oss på stand under fagmøte i genetikk 13. - 14. november i Skien.
Future of Omics Conference - Nordic Edition

Future of Omics Conference - Nordic Edition
Join us on November 4th at Karolinska Institute in Stockholm for the Future of Omics Conference - Nordic Edition.
Lederdagene 2024

Lederdagene 2024
Møt på stand under Lederdagene 28. - 29. oktober på Scandic Havet i Bodø. Velkommen til oss!
Høstkonferansen i mikrobiologi

Høstkonferansen i mikrobiologi
Møt oss på stand under Høstkonferansen i Mikrobiologi 17. - 18. oktober i Kristiansand. Velkommen til oss!
Trønderkurset Helsesekretærforbundet 2024

Trønderkurset Helsesekretærforbundet 2024
Møt oss på stand i forbindelse med Trønderkurset på Scandic Hell Stjørdal, arrangert av Helsesekretærforbundet 21-22 september 2024.
Opplandene Veterinærforenings høstkurs

Opplandene Veterinærforenings høstkurs
Vår produktsjef og veterinær Marit Bergseng tar kursdeltagere imot på stand og gleder seg til faglige diskusjoner under årets kurs på Scandic Lillehammer. Møt oss på stand!
Noklus - Kurs i laboratoriemedisin - Oslo Kongressenter

Noklus - Kurs i laboratoriemedisin - Oslo Kongressenter
Møt våre produktsjefer Martin Oma og Nina Rismyhr under kurset i laboratoriemedisin organisert av Noklus.
Noklus - Emnekurs i laboratoriemedisin - Bodø

Noklus - Emnekurs i laboratoriemedisin - Bodø
Møt vår produktsjef Nina Rismyhr under kurset arrangert av Noklus, 11-12 april på Quality Hotel Ramsalt i Bodø. Velkommen til vår stand.
Veterinærdagene 2024

Veterinærdagene 2024
Våre produktsjefer Marit Bergseng og Martin Oma gleder seg til å møte kunder under Veterinærdagene i Bergen, Quality Edvard Grieg hotell. Velkommen til vår stand!
Infobruk konferansen 2024

Infobruk konferansen 2024
Martin Oma og Nina Rismyhr ser frem til møte våre kunder i primærhelsetjenesten, under Infobruk Konferansen på Clarion Hotel Bergen Airport. De vil demonstrere blant annet celletellere og HemoCue-produkter.
Noklus Høstkurs Telemark - Skien

Noklus Høstkurs Telemark - Skien
Et av fagtemaene under kurset er "Celletellere" og våre produktsjefer Nina Rismyhr og Martin Oma vil presentere våre to ulike modeller på standen. Våre produktsjefer har mange års erfaring med hematologi og celletellere , så det vil være anledning for å spørre alt det man lurer på i dette feltet.
NCGP 2022 - 22 nd. Nordic Congress of General Practice

NCGP 2022 - 22 nd. Nordic Congress of General Practice
Vi har gleden av å dele stand med en av våre leverandører, HemoCue – under den 22. nordiske kongressen for allmennmedisin som holdes i Stavanger 21 – 23 juni 2022. Her vil vi presentere produkter fra blant andre HemoCue og Horiba. Vårt hovedfokus vil være på hematologi og hvilken nytte allmennleger kan ha av en celleteller eller en leukocytteller. Velkommen!
Noklus kurs i laboratoriemedisin (2)- Utstilling- Holmen Fjordhotell

Noklus kurs i laboratoriemedisin (2)- Utstilling- Holmen Fjordhotell
Du vil treffe våre produktsjefer Martin Oma og Nina Rismyhr på stand under kurset i laboratoriemedisin arrangert av Noklus. Kom gjerne innom for å se våre systemer innen hemoglobin- og glukoseanalysering og få svar på alt du ønsker å vite om celleteller. Velkommen!
Noklus kurs i laboratoriemedisin - Utstilling- Holmen Fjordhotell 1

Noklus kurs i laboratoriemedisin - Utstilling- Holmen Fjordhotell 1
Du vil treffe våre produktsjefer Martin Oma og Nina Rismyhr på stand under kurset i laboratoriemedisin arrangert av Noklus. Kom gjerne innom for å se våre systemer innen hemoglobin- og glukoseanalysering og få svar på alt du ønsker å vite om celleteller. Velkommen!
Noklus-kurs Røros - Utstilling

Noklus-kurs Røros - Utstilling
Møt vårt primærhelsetjeneste-team på utstillingen i forbindelse med Noklus-kurset for leger og medarbeidere på Røros hotell. De presenterer produkter innen infeksjonsdiagnostikk, anemiutredning og diabetes.
Noklus Emnekurs i laboratoriemedisin i Tromsø - Utstilling

Noklus Emnekurs i laboratoriemedisin i Tromsø - Utstilling
Kom og møt vår produktsjef Nina Rismyhr i Tromsø, på emnekurset arrangert av Noklus. Hun vil presentere flere av våre systemer, blant annet Quidel QuickVue Strep A In Line - hurtigtesten med et unik format.
Veterinærdagene - Utstilling - Scandic Hotel Lillehammer

Veterinærdagene - Utstilling - Scandic Hotel Lillehammer
Våre produktsjefer Marit Bergseng og Martin Oma gleder seg til å møte dere på stand under Veterinærdagene 2022 i Lillehammer. De vil presentere flere av våre systemer, blant annet den unike og nette multianalysatoren Eurolyser Cube Vet. som tilbyr flere viktige tilleggsparametere.